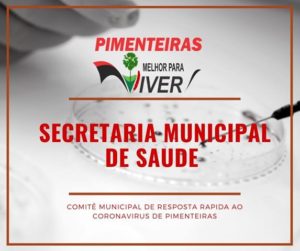

Prefeitura de Pimenteiras confirma concurso para o dia 11 de junho
 A Prefeitura Municipal de Pimenteiras divulgou uma nota nesta sexta-feira (19) confirmando a realização do Concurso Publico Municipal que será realizado pelo Instituto Legatus no próximo dia 11 de junho do corrente ano.
A Prefeitura Municipal de Pimenteiras divulgou uma nota nesta sexta-feira (19) confirmando a realização do Concurso Publico Municipal que será realizado pelo Instituto Legatus no próximo dia 11 de junho do corrente ano.
O motivo da nota é para desmentir uma informação que foi veiculada nas redes sociais de que o concurso teria sido cancelado pelo Tribunal de Contas do Estado (TCE-PI).
A prefeitura lamentou a postagem e atribuiu a sua autoria a pessoas que ainda não desceram do palanque politico. Afirmou ainda que tal informação não prejudica a Prefeitura Municipal e sim as pessoas inscritas no concurso.
“Por ignorância ou má-fé, tem-se espalhado o boato de que o Tribunal de Contas do Estado teria cancelado o certame. É preciso ter consciência que esse tipo de notícia, sem qualquer fundamento, não prejudica a Prefeitura Municipal, alvo daqueles que, certamente inconformados com a vontade soberana do povo, ainda permanecem nos palanques eleitorais. O boato, na verdade, prejudica, sobretudo os cidadãos de nossa cidade, que podem deixar de efetuar suas inscrições e de ter a oportunidade de ingressar no serviço público por mérito próprio” diz a nota.
A prefeitura tranquilizou os inscritos no pleito. “Assim, a Prefeitura Municipal tranquiliza todos os candidatos inscritos, bem como aqueles que têm a intenção de se inscrever, aproveitando ainda para desejar uma boa jornada de estudos e uma boa sorte no certame” pontou.
Confira a Nota
NOTA AO PÚBLICO
A Prefeitura Municipal de Pimenteiras informa que o concurso público instituído pelo Edital nº 01/2017 se encontra com seu andamento REGULAR. Não houve qualquer decisão, de qualquer órgão que seja, determinando sua suspensão ou cancelamento, até porque não há qualquer motivo para tal.
Por ignorância ou má-fé, tem-se espalhado o boato de que o Tribunal de Contas do Estado teria cancelado o certame. É preciso ter consciência que esse tipo de notícia, sem qualquer fundamento, não prejudica a Prefeitura Municipal, alvo daqueles que, certamente inconformados com a vontade soberana do povo, ainda permanecem nos palanques eleitorais. O boato, na verdade, prejudica sobretudo os cidadãos de nossa cidade, que podem deixar de efetuar suas inscrições e de ter a oportunidade de ingressar no serviço público por mérito próprio.
Reiteramos: não houve cancelamento do concurso pelo TCE. A imagem que usam para querer fazer crer que teria ocorrido o cancelamento, na verdade é da primeira licitação que havia sido instaurada pelo município. Naquela ocasião, diante da falta de publicação do aviso de licitação em jornal de grande circulação, a própria Comissão de Licitação cancelou a primeira licitação, para que todos os procedimentos legais fossem devidamente obedecidos. Em seguida, uma nova licitação foi realizada, a qual se encontra devidamente “Finalizada”, cumprindo todos os requisitos e formalidades estabelecidos em lei e pelo TCE.
Assim, a Prefeitura Municipal tranquiliza todos os candidatos inscritos, bem como aqueles que têm a intenção de se inscrever, aproveitando ainda para desejar uma boa jornada de estudos e uma boa sorte no certame.
Francisco Alex Soares Pereira
Secretário de governo